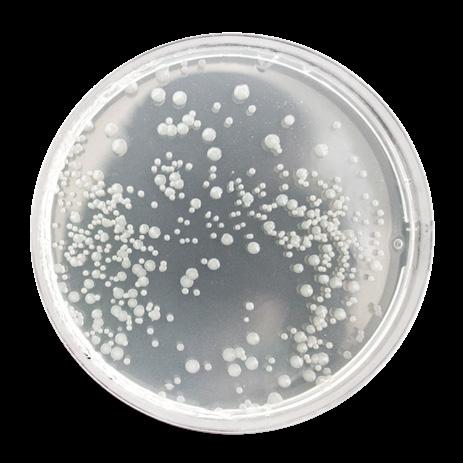

![]()









Live Oak School supports the potential and promise of each student.
We provide a strong academic foundation, foster skills to effect change, and develop courageous and conscientious learners from all backgrounds.
We inspire students to advance equity and inclusion, to act with compassion and integrity, and to pursue a lifelong passion for learning.


Dear Live Oak Community,
Welcome back to school with the Summer 2025 issue of Live Oak Magazine. We have had the summer to reflect on the learning, growth, and connection that happened over the past year. In this issue we spotlight the range of transformative experiences that engage Live Oak students and the experiences that have led people to Live Oak. We hear from Live Oak alums who are taking valuable insights and lessons from their experience at Live Oak and are showing the world their talents, ambitions, and potential. We recognize and acknowledge that our experience makes us better: more aware, more empathetic, more driven, and more informed.
Our students are shaped in countless ways by their learning experiences at Live Oak; our parents and guardians bring elements of their own life experience when their families enter Live Oak and leave elements behind that enrich our community; our faculty and staff engage in experiences that make them better educators and deepen their connections with our students. They shape who we are, who we strive to be, and the types of leaders we become.
Experiences open our eyes and our minds. Getting the chance to experience some bit of history first-hand opens our students’ eyes to new perspectives and realities. The range of experiential learning our students do throughout the year puts students in positions to learn by doing, to meet people, to try things, to see things for themselves. This past year our eighth graders experienced a new trip that brought history to life. We are excited for you to see what they took from that experience.
Experiences unite us. Live Oak has many traditions that bring the community together. Among Live Oak’s numerous long standing traditions is our annual Camp Live Oak. These experiences connect students, parents and guardians, and faculty and staff. People look back and say, “Remember that time at Camp…”
I hope you enjoy the summer issue of Live Oak Magazine! We are looking forward to an inspiring 25/26 school year full of new experiences and learning opportunities!
Warmly,

Virginia Paik P’20 Head of School

The AI Experience How incorporating artificial intelligence at Live Oak offers deep learning potential 14
Retracing the Path Towards Civil Rights
The Class of 2025 embarks on a tour through changemaking history
32
Alumni Spotlight: Young Alumni Changemakers
Nala Urrutia ‘21 and Justin Babler-Kuebler ‘21 lead with inclusion in their high school communities
A Campout for the Community Live Oak’s tradition of an all-school camping trip offers growth and connection 26
36 Class of 2021 Reunion + Alumni News & Notes Stay connected with Live Oak graduates 38
42 What I Learned in 2024-25 Students reflect on a year of challenge and growth made possible by the Live Oak community’s philanthropic support
Grandparents & Special Friends Day A Live Oak tradition celebrating community
3 What’s Brewing at Live Oak News, notes, and happenings around Live Oak 8 Feminist Alliance Space to connect, learn, and inspire supports student action Inspire Every Learner Activate Changemakers
Community Voices: Belonging at Live Oak A Live Oak parent perspective on inclusion, joy, and purpose 28 Step Up & Graduation 2025
Celebrating our recent graduates on Mariposa Street
40
Legacy Gift from the Class of 2025
STEM spaces on campus are undergoing an upgrade to support innovative learning
44
Mistakes are Magic:Creating the Culture to Try Again Finding the right approach to teaching a lesson sometimes takes multiple attempts



Every day at Live Oak School students think deeply, follow their curiosity, and stretch themselves to master new skills. As part of a joyful community, they are known well and valued for who they are. Live Oak’s mission, vision, and values are strengths to be secured. The continuous development of Live Oak School and our academic program is rooted in five Strategic Directions. All of them ask that we extend the potential and promise of Live Oak School in new and exciting ways.

Advance Equity, Increase Diversity, Deepen Inclusion

Promote the Live Oak Way




The Lightning capped off a historic winter sports season by claiming three league championships–each in undefeated fashion. It was the first time that Live Oak has won three basketball titles in the same season and continues a string of five straight seasons with at least one Live Oak hoops team claiming a league crown.
The Live Oak varsity girls capped off a perfect 8-0 season with a 35-19 win in the finals against Burke’s, while the seventh grade JV boys rounded out their season with a perfect 8-0 record of their own after battling back from an early deficit to take control of the game down the stretch in their 52-43 championship win over The San Francisco School. Rounding out the action were the JV girls, who topped Synergy 28-19 in the championship to conclude their own flawless 8-0 season.

This fall, Live Oak will expand its Spanish instruction to include all grade levels from kindergarten through eighth grade. Most recently, the Spanish program began in fourth grade. This expansion allows for our youngest learners to build a strong foundation of language development from the outset, facilitating even deeper, more comprehensive language exploration as our students gain more sophisticated skills through middle school. In addition to the opportunity for deeper language acquisition, Live Oak’s Spanish curriculum will continue to integrate cultural learning, appreciation, and celebration, offering more ways in which Live Oak students can understand diverse perspectives and experiences.


All six of Live Oak’s futsal teams qualified for the SFAL playoffs this past spring, with the varsity girls highlighting the group by advancing all the way to the league title game where they lost to CAIS by a final of 10-2, finishing the year at 7-1 overall.





The cast and crew of the spring play put on five sold-out performances of “The Princess and the Pea” in April. Eight trolls, four big dance numbers, and 10 loads of laundry were just some of the ingredients of another great production.
Like all Live Oak productions, the students run the show, selling concessions, operating the tech table, managing backstage, and more. These middle school performers came up watching the pro ductions year after year as lower school stu dents. Now getting their chance to take the stage, they delivered!
Commented Drama Teacher Stephanie Temple after the shows: “In this unique version of the play our wonderful family of misfits learned to let their freak flags fly! Congratu lations to this group of eighth graders completing their fi nal shows at Live Oak!”
Live Oak is excited to welcome new division leadership for the 2025-26 school year with Regina Hardatt beginning her tenure as Live Oak School’s incoming lower school division director, complementing fellow newcomer Asha Weber, who begins as middle school division director. Hardatt served most recently as the assistant lower school director for inclusive teaching & learning at The Pingry School in New Jersey from 2021-24. A two-time graduate of St. John’s University with degrees in Childhood and Secondary Education, Hardatt completed her Ed.D. in Educational and Organizational Leadership at the University of Pennsylvania.
Weber comes to Live Oak after most recently serving as the community school director for the Seneca Family of Agencies in Richmond, CA. She spent six years in the classroom, teaching sixth through eighth grade math and science. A General Science & Computer Science Information Systems major at Johnson C. Smith University, Weber went on to earn her M.S. in Educational Technology & Leadership from Cal State East Bay and her multiple subject teaching credential from Cal State TEACH, Monterey.

Community Assembly





MS Division Director

Throughout the school year, Community Assemblies are woven into the weekly lower school Friday assembly cadence, providing opportunities to celebrate and teach about the range of identities our students and their families bring to school. This past spring featured the first Community Assembly highlighting neurodivergence, giving the stage to lower school students to teach their peers about the unique ways they learn and how their peers can better understand and support their learning.
Live Oak is rolling out new approaches in the 202526 school year to strengthen student learning and well-being. Recognizing that children learn best when they feel safe, understood, and connected in their school environment, these program innovations aim to create an environment where every student can thrive academically and socially.
One key initiative is the creation of an Office of Diversity, Equity, Inclusion, and Belonging, with the goal of ensuring all students feel a strong sense of belonging, build confidence, navigate differences, and deepen connections with peers and teachers. Wil Dioniso, who has been part of the Live Oak community since 2010, will become Live Oak’s first dean of student inclusion and belonging, working with Adrian Takyi, Live Oak’s director of diversity, equity, inclusion, and belonging to ensure that every student has the skills and pathways for them to fully engage with classroom and community experiences.
A second major investment in student learning is the schoolwide implementation of the Collaborative Problem Solving approach through a new threeyear partnership with Think:Kids. This initiative will train and coach faculty to integrate Collaborative Problem Solving approach into their work with students, building cognitive flexibility and problem solving skills to help them navigate challenges in and out of the classroom. Leading this work will be our deans of wellness–Gillian Lait in lower school and Camilo Coelho and Neil Cashman in middle school–promoting a healthy school climate where support services are integrated into daily learning and social experiences.
Through these program innovations, Live Oak is deepening its commitment to evolving the systems and structures of support that nurture each student’s academic growth, emotional well-being, and sense of belonging, building a foundation for lifelong learning.





Live Oak welcomes a group of new faculty and staff that comes in ready to make an impact with our students, bringing many years of diverse experience and mission-driven work to their roles. Join us in welcoming our new educators!














Live Oak Magazine is produced by Live Oak’s Advancement Office. We value the accuracy of the information published in our magazine, so please contact communications@liveoaksf.org with any errors or omissions. We always welcome updates and content from our community far and wide; please submit story ideas and alumni updates to the email address above. Moved or planning to move? Provide us with your updated address. The magazine is also available digitally on the Issuu.com platform.
This issue was designed by Uma Das O’Toole and printed by Colorprint. Photography contributions in this issue include: Minerva Cerón, Tom Crabtree, Andy Denmark, Wil Dionisio, John Gaudino, Amy Hansen, Ruqoiyah Ghe-Huang, Catharyn Hayne, Ethan Kraska ‘23, Kathryn Kundrot, Justin Mears, Lily Panetta, Stephanie Temple, Todd Tokubo, Diego Villegas ‘16, Lena Wilson ‘21, and Carlos



Celebrating Their 25th Year at Live Oak: Celebrating Their 20th Year at Live Oak:


Celebrating Their 10th Year at Live Oak


Celebrating Their 15th Year at Live Oak:

Heading into the 2025-26 school year, we celebrate the following faculty and staff for reaching milestones in their respective tenures at Live Oak. Their dedication and expertise have shaped the experiences of countless students and advanced our mission. We appreciate all they contribute and look forward to many more years of their impact at Live Oak!
Their






Access the digital version of this magazine and recent issues on Issuu.com.



The Feminist Alliance brought middle school students together to learn about, celebrate, and teach about female empowerment. The genesis of the club was student-initiated as many students craved an outlet to exchange ideas about feminism and learn how they might be able to contribute towards a positive impact in educating others and furthering access to opportunities for everyone. The group, led by faculty advisors Sydney McGhie, Katie Moore, and Kathryn Kundrot, included a roster of over 20 regular attendees who met to engage in activities that deepened their understanding of feminism, its notable advocates, and ways they could open those conver-
sations about feminism to their peers. The strong sense of purpose that Live Oak students have gained from participating in affinity spaces like the Feminist Alliance remains a core piece of their overall learning experience.
“At Live Oak we are taught at a young age to have our own perspectives on things,” says Serenity P. ‘25. “One of the important things that these spaces provide is a chance to help other people outside of Live Oak do the same by knowing how to come together with other people and talk about a topic that means a lot to you.”
“I got to learn about a lot of activists that I never knew before and I don’t think I would have been able to do that anywhere else,” adds Selma L. ‘25. “It has been great to see all these women who have done so many powerful things. I think it’s really important that we show other people that it’s possible for girls and women to do impactful work.”
Zoe L. ‘27 was one of the students
who started the club, inspired by her grandmother’s own fight for equal opportunities. Zoe’s grandmother, Gail Stephens, came in to share her story with the club one day, recounting her experience entering the workforce when the career pathways for women were generally limited to being a teacher, nurse, or secretary. By eventually becoming a psychiatrist, Stephens shattered barriers and helped Live Oak middle school students gain valuable perspective on how far women have come over the generations and reinforcing the need for students to become the next wave of activists to effect positive change and continue the evolution of societal norms and expectations around gender.
“My grandmother has been a part of this movement since she was in college,” explains Zoe. “We had her come in to speak one day and it was really interesting because I already knew a lot about her, but I learned so many new things. With this group, I think it’s been valuable to be able to unite over one topic, but spread out into different corners




of the topic by learning about real-life figures. It’s fun to be in one room sharing this experience and figuring out what we want to do to help and to be able to experience feminism the way we want to experience it.”
One of the projects the group completed involved researching notable feminist activists both past and present. Students took away important lessons on the long term battle of feminism and how the movement has grown and evolved over time. They presented their research at a middle school assembly this past spring and found that many of their peers took some important things away from it.
“Some people came up to me in the hallway and told me they hadn’t known those things before or hadn’t understood that perspective,” says Aya M. ‘27. “Helping people see the stories behind feminism and the impact it has on us today helps us understand why it really matters.”
As a shared project, and a tangible symbol of the group’s ethos,

members of the Feminist Alliance screen printed their own shirts with the phrase, “Shatter the Glass Ceiling.” In addition to serving as an aspirational rallying cry, the shirts reinforce the feeling of student empowerment that is fostered within this and other affinity groups at Live Oak. Their aim to work collectively in pursuing, developing, and refining their beliefs helps serve the whole as much as the individuals involved.
The Feminist Alliance will continue into this next school year and, as many of the club’s members hope, expand its reach to a broader audience moving forward. The recent graduates from the group expect to bring their spirit of social activism to their respective high schools.
“It is so cool to see how students from different grades uplift each other,” says Daria B. ‘25. “I hope this continues here and in our high schools, and spreads out in the world. I think it’s really important to have these types
of groups where people in the community can have a spotlight on parts of their identity that are really important to them and to acknowledge these things because we want to continue to improve our society. It’s important to acknowledge who we are and what our values are.”
“I hope that when I return to Live Oak I will see this club still going,” adds Mabel R. ‘25. “To research all these people who have given so much, it makes me really appreciate how their contributions have brought us here today.”
This shared sense of purpose and perspective serve as crucial learning opportunities that support Live Oak students’ growing knowledge and leadership skills. Their passions will continue to drive these members forward towards transformative changemaking action.







Lianna Kali, Director of Instructional Innovation
It feels like just yesterday we were asking each other, “Have you tried ChatGPT yet?” Now, less than two years later, we’re grappling with how to meaningfully incorporate this technology into our curriculum while staying true to our core educational values.
At Live Oak, we pride ourselves on our ability to differentiate instruction for our diverse student body. AI is a powerful tool to enhance this strength and make resources available to students in a way that was previously impossible. For example, we know that cross-curricular learning deepens understanding for students, but finding grade-level appropriate texts that combine science and reading has always been a challenge. Now we can use these tools to rewrite a high school text for third grade comprehension or provide tailored scaffolding questions for individual learners. These possibilities excite me as we design our academic program to meet each student’s unique needs.
Live Oak’s curriculum is rooted in constructivist practice, emphasizing authentic experiences and hands-on learning. As we introduce AI tools, we’re constantly asking ourselves critical questions: Where does AI fit into this process? How do we maintain
the integrity of our program while embracing these new technologies? These questions support teachers in designing learning experiences that make intentional choices about when learning should be AI-assisted vs. AI-resistant and what are the best practices to do so.
One of our primary concerns is ensuring that AI doesn’t oversimplify the learning process. True learning often happens in moments of productive struggle. When what we know and feel comfortable with meets our growing edges. Where we have to push harder, think more deeply, and expand our skills and thinking to the next level. As we plan how to use these tools with students, we have to consider ways to maintain opportunities for developing their






struggling to find sources related to
this topic. MagicSchool was able to help her find specific women to research in more depth and pointed her toward sources where she could continue searching for information. As she and others went through this research process, teachers were able to monitor their usage, get feedback on student engagement, and receive suggestions on ways to offer constructive support based on their searches.
Student safety and privacy are paramount in our approach. We’ve implemented an AI Acceptable Use Policy for both students and faculty, providing clear guidelines on appropriate AI tool usage. We use a stoplight metaphor to explain when and how AI use is allowed on an assignment–green for what’s allowed, yellow for when students should check with a teacher, and red for what’s not allowed. Our partnership with MagicSchool AI ensures that AI use for school purposes is done with a tool that provides transparency to teachers and safe interactions for students.
Reflecting on my past experiences with emerging technologies, I think back to my time at the Exploratorium during the rise of makerspaces. We believed that hands-on building could be both a meaningful and enjoyable way for students to literally and metaphorically construct their understanding of a concept or idea. In the excitement of this new approach, we saw organizations rush to buy all the tools and materials to build a makerspace, but not pause to consider what it would take for the space to thrive and sustain learning.
Through our professional development work with teachers, librarians, after-school program leaders, and other museum professionals, we emphasized that makerspaces aren’t just about the stuff–they’re about the experiences educators design to create conditions for deep student learning. We see parallels between the excitement and rapid change of makerspaces then and AI now. It’s a reminder that just having access to an AI tool won’t ensure innovative learning or engagement. The role of the educator remains critical in providing the appropriate scaffolding, structures, prompts, and constraints to make learning meaningful.
I’ve always viewed technology in schools as a means for learning, and not an end to learn in itself. At Live Oak, AI and all technologies in the classroom will continue to be tools for creative expression, critical thinking, thoughtful reflection, and rich collaboration. Imagining the future of AI and education, we worry about deepfakes and misinformation. The environmental impact a single query has is troubling. But we’re guided by the belief that humans are infinitely creative and have the ability to shape our world to be a more just place. With this vision, AI can become one of the many tools in our toolbox–along with craft, song, writing, inquiry, curiosity, collaboration, and others–to make schools places of deep learning that activate the changemakers who will create that just world.

Live Oak School is committed to fostering an innovative learning environment that integrates technology responsibly and ethically to enhance teaching and learning experiences. AI tools offer opportunities to support creativity, critical thinking, and efficiency, but their use must align with our mission, values, and security standards. In developing a policy the goal is to establish clear guidelines for faculty regarding the ethical and effective use of AI in their professional responsibilities.

Faculty and staff must use AI in ways that uphold academic integrity, privacy, and security.

AI is a tool to enhance, not replace, human thought, creativity, and relationships.

Faculty and staff should model responsible AI use and communicate expectations clearly to students and colleagues.

AI-generated content should be critically reviewed and used responsibly, acknowledging its biases and limitations.
Take a trip through the South with our eighth graders as they offered their real-time observations and reflected on their week experiencing the powerful landmarks that symbolize both the historical and ongoing struggle to achieve equal rights for all Americans.
This spring, Live Oak’s eighth graders embarked on a five-day trip through the South to visit pivotal historical landmarks of the Civil Rights Movement. For many years, the tradition was to visit Washington D.C., but this shift brought the experience into even closer alignment with the
to examining global histories of colonialism, conflict, and peace, and returning in eighth grade to studying the US Constitution, the Civil Rights Movement, and how opportunities to engage in civic life are granted. The Civil Rights trip brought these lessons to life. Students walked the streets,
to see the Civil Rights Movement not only through the iconic stories of Martin Luther King Jr. and Rosa Parks, but also through the collective actions of individuals across race, gender, and class. This message resonated with this class who is inspired to pursue change in their own ways.


And because this was a milestone–marking the close of their time at Live Oak–there was also space for joy, connection, and celebration. Time together on buses, over meals, and in new places, deepened friendships and created moments to integrate the powerful learning



Take a trip through the South with eighth grader Magnolia D. as she shares her observations and reflections on her week experiencing the powerful landmarks that symbolize both the historical and ongoing struggle to achieve equal rights for all Americans.
“It was really powerful to know that so much history was made on the very ground we were standing. I feel like Live Oak has taught me so much about Martin Luther King Jr., but it was truly a different experience being there. The most impactful part of the day for me was definitely visiting the Ebenezer Baptist Church. We got the chance to hear stories by a local park ranger about Martin Luther King Jr. and Sr. Although some of the events that happened at that church were awful, so much of what made our history today happened in that very church. Overall, the whole experience was very moving that gave me light into the life of MLK Jr. and his family. This was a great way to start off our trip strong!”




“Today started bright and early with a driving tour of Montgomery. We got a sneak peak into the life of someone living in Alabama back in the time of the Civil Rights Movement. We then followed the path on the Selma-to-Montgomery March starting at the Edmund Pettus Bridge. Our tour guide, Jake, showed us the five-day trek and each of the campsites along the way. He was really inspiring to hear from, especially because he got the opportunity to walk on the fourth day of the march when he was a child. He told us about his experiences seeing both the violence but also the strong spirits and community determination. Today was a long, but super interesting and powerful day. Without our tour guide Jake this trio wouldn’t have been complete; he truly took us back to the time and place where these historical events occurred. He told us about what it was really like and it was really impactful how he was able to speak from experience. We ended the day by going bowling, and it was a really fun class bonding experience. I have really enjoyed being able to spend so much time with my friends and my class on this trip!”


“Our first stop was at the Civil Rights Institute. This museum was one of my favorites by far; it was interactive and super engaging. Personally, this museum was really powerful and it was both interesting and heartbreaking to see horrific photos of police brutality and hear voice recordings of young children confined by the laws of segregation. We’ve always heard about the extreme differences between ‘colored’ and ‘white’ areas but to be able to see actual preserved objects like water fountains truly gave a different perspective on the extreme injustice. This museum was right next to the Baptist church where we learned the horrific history of four young girls who were killed by a bomb by a member of the KKK. It just makes you think about how all of the injustice from the past still impacts our history today. After all of the museums, our class went to a Montgomery Biscuits baseball game. It was super fun and the whole class had a great time bonding and watching the team play.”





“Our fourth and final day of our trip started with a ‘time machine bus’ that took us back to the year 1900. It was really impactful to see the actual faces of people dealing with extreme segregation around the time of the Montgomery Bus Boycott. Shortly after the Rosa Parks Museum we headed to the Peace and Justice Memorial. It was heartbreaking to see the pure numbers of African Americans lynched in such a short period of time. It was actually insane to see some of the reasons people’s lives were taken, like reporting white children who threw rocks at them or for simply voting. Personally, this was the most powerful and shocking of the museums we visited on the trip. There were heartbreaking poems of mothers who had their children stripped away from them and statues of families chained to walls. This museum was so real, and it’s so hard to believe that this truly happened in history; that the streets we walk were witness to so much injustice.”

The experience was nothing short of inspiring. Many Live Oak students had never visited the South. Places like the Edmund Pettus Bridge and Ebenezer Baptist Church were locales from research papers and history books, but now they have come to life. Seeing these and other sites along the way left a meaningful mark on the Class of 2025. Hear from some of the students as they share their takeaways from the trip.












“It was very powerful, very eye-opening. Some things we saw there were actually pretty scary to see in person. We learned some deeper, more raw details that we hadn’t learned in class. It seemed like we knew so much already, but as we experienced different museums and sites we heard more and more stories from locals and people who had been through the Civil Rights Movement. I came away understanding that, while you think you might know a lot, there is always more to learn and it’s important to be open-minded and receptive to new information.”
“One of the highlights for me was visiting the MLK Jr. Historical Park, specifically seeing MLK Jr.’s church because it gave me a more in-depth view of what he did, where he came from, and what he helped accomplish. Visiting the Sixteenth Street Baptist Church in person and hearing the story of how it was firebombed and young girls died made me put in the most reflection. It made me think about how bad racial conditions were at that time. I knew there was hostility, but I didn’t think the hostility was at those levels.”
“We went to a lot of places that we had learned about in class, and it was really interesting to see how things translated from the book to real life. One thing I found really interesting were the sheer amount of churches that were used during the Civil Rights Movement as places to gather and learning about how people’s religion and faith guided them during this time was really inspiring. It was also so shocking to think about how relatively recent this was. This is not ancient history; this was happening 70 years ago. We met people who lived through the Civil Rights Movement, which is so crazy to think about. The trip really put into perspective the privilege that I have in my life. It showed me that I have to come to terms with my own privilege and acknowledge it, while trying to use that knowledge to help.”
Nate S.
“The National Memorial for Peace and Justice was very well put together, and also very crushing. It really brought to light the sheer number of people who had been lynched, but also the humanity of those people. It showed how much injustice thrived in that era. It’s both history and current events. When I went to the South I expected to find people who were very different from me, but no, that wasn’t the case whatsoever. We are all human and we’re all sharing some level of similar experiences. It’s going to change how I think about the world and how I critically think about future experiences where I am going somewhere new.”
Nick E.
“We went to the Legacy Museum the last day and it was one of the saddest museums I have ever been to; it definitely hit my heart a lot more than I thought it would. We also got to go inside actual tiny plantation buildings that were home to enslaved people, which were just terrible. The museums were so creative in the way that they shared this information. For example, visiting the National Memorial for Peace and Justice and seeing how they displayed victims’ names written on pillars suspended from the ceiling just made the whole experience that much more powerful.”

“I really liked how we built up how deep the visits got each day. It was interesting to end with the Legacy Museum and see how it connected things like the slave trade going all the way back to the 1600s. Overall, the trip was a good balance of learning about the Civil Rights Movement and making memories with our friends. What I would tell next year’s group of eighth graders to get the most out of the trip is to talk to your friends on the bus while you’re driving from stop to stop about what you found most impactful so you can take that time to really reflect and process it more.”
Genevieve S.
Bustling chatter and laughter filling cabins, dusty boots trudging along tree-lined trails, the crescendoing whiz of a zipline flying overhead. These are just some of the sights and sounds that define Camp Live Oak. Since the school’s beginning, Live Oak families have shared the special tradition of a springtime camping outing. Long a staple of Live Oak’s academic program, Camp Live Oak provides a very special experience that engages students and their families in a oneof-a-kind community-driven shared experience.
Starting as a much smaller undertaking in the School’s nascent days in the early 1970s, the Camp Live Oak experience has evolved along with the growth of the school, finding new locations as the school has outgrown camps over the years. The annual camping outing has always signified the end of the school year, typically taking place between Memorial Day and Step Up and Graduation ceremony in early June. In decades past, Camp Live Oak actually marked the official ending of the school year, coming after graduation and sending students and families off to summer break as they packed up their tents and sleeping bags.
With the 2025-26 school year marking her 48th year, Director of Learning Services Mary Ann Chin Ng stands as Live Oak’s longest-tenured employee. Chin Ng has experienced first-hand the evolution of the Camp experience and has seen the value that Camp brings to the overall Live Oak experience. “Kids get a chance to explore nature and be in a place without walls,” explains Chin Ng. “For some kids, that’s where they really thrive and shine. There are other kids who have never had a chance to sleep away, go canoeing, or explore in this way, so it’s all about seeing kids in the outdoors with their friends just enjoying the experience and being able to be themselves.”

Take a tour of Camp Jones Gulch, a YMCA-run year-round camp in Pescadero–an hour south of Live Oak’s San Francisco campus–that has been home to Camp Live Oak since 2018, and you’ll see classes taking hikes through the redwoods, groups of students splashing in the pool, adventurers clipping in their harnesses to ascend the 50-foot climbing wall, and staff, parents, and guardians conversing, organizing, and recovering within “Central Central,” the main hub of activity in the center of camp.


Clusters of cabins spread out from Central Central, linked by worn dirt paths and the one paved road that traverses camp.
It is by immersing themselves in this different environment that students and parents alike are coaxed out of their routines, drawn to new experiences and challenges that serve as the source of so many memorable firsts.
“Camp Live Oak allows you to try things that are normally outside your comfort zone,” says Spanish Teacher Ashlley Belcher ‘07, who logged her first time ever camping while a student at Camp Live Oak. “It also gives you the opportunity to connect and deepen relationships with your friends in a completely different setting. I remember my first experiences with horseback riding, tower climbing, archery, ziplining, and gardening. I also enjoyed journaling about nature and wrote a couple of poems inspired by the surroundings.”
Anika P. ‘25 offers a similar sentiment, reflecting on her final trip to Camp Live Oak this past spring, “What’s unique is that you get to be in this new environment where you can be active in things that you don’t normally do in the school building.”
In the early years of camp, teachers took on the responsibility of planning and leading the various hikes, excursions, arts and crafts, and activities during camp. Nowadays, the operation has expanded, but still relies heavily on the efforts of the entire Live Oak community. With numerous volunteer roles throughout the three-day, twonight outing, the willingness to get involved adds deeper layers to the
experience shared between students and their parents and guardians.
“I began volunteering in 2018 and have served as a co-chair of Camp since 2021,” says Erin Dolly, whose son Connell is a rising eighth grader. “There is nothing better than when the entire school is together in-person at one campsite. Getting to spend time with my son and his classmates, with Live Oak’s dedicated staff, teachers and administrators, and building friendships and lifelong memories with fellow parents has been such a meaningful part of our Live Oak experience.”
Laura Oppenheimer has joined Dolly in helping coordinate Camp in recent years. She recounts how much the experience helped her son, Eli, a rising fifth grader, branch out and challenge himself in new, meaningful ways. “Eli is 100% an indoor kid,” explains Oppenheimer. “At Camp Live Oak, he has to leave his comfort zone–but he does that with the support and friendship of his classmates. In second grade he looked

and immediately said, ‘no thanks.’ But on the drive home, he reflected that he wished he had tried the rock-climbing wall. A year later, he stared up at the wall and committed to trying. He was so proud of himself for making progress and climbing. This is what I love about Camp Live Oak.”
One of the highlights of Camp–and one of the all-camp collective experiences–is the annual Talent Show. Evoking an open-air amphitheater feel, students take turns sharing their dance talents, songs, comedy, musical prowess, and so much more for the packed crowd.
“The Talent Show is more than just performance,” explains Director of Extended Day Programs Dorothy Martinez, who has been involved in the planning and execution of the Talent Show over her 19-year tenure at Live Oak. “The Camp Talent Show experience can have a lasting impact, helping students grow both personally and academically, which I believe is one of the most meaningful ways to approach outdoor education. The show encourages self-discovery and creates a space where students can take risks, explore their interests, and feel proud of who they are.”

What makes this all possible is the shared experience of taking these challenges alongside one’s peers. Having the reassurance that you are all in it together and whether you love it or hate it, you have at least tried it and gained something from the experience. This is a feeling shared by many students during their time at Camp that reflects the supportive environment of risk-taking
that Live Oak strives to create in its classrooms day to day.
“It feels really exciting,” says Anika P. “My friends were there as I was trying these new things, so I wasn’t alone. I think Camp has just been a really amazing experience. Especially how we ended with the Talent Show, seeing people express themselves through their talents is just really cool to see and I’m going to miss it.”

Since attending her first Camp as a third grade teacher in 1978, Chin Ng quickly became the de facto arts and crafts czar, teaching generations of students her signature Camp creation: Beadie Buddies. More than just a time-filler between zipline and swimming, the arts and crafts creations have come to represent the innovation and creativity that Live Oak students show in the classroom.
“I really enjoy watching the kids create and the joy it brings them when they learn a new craft and make something,” says Chin Ng. “You give them the raw materials and see what they can come up
with. What has been really fun recently is that the kids are creating their very own Beadie Buddies patterns. They are really proud of what they can do, especially when they see that the pattern they came up with is used as a kit for other kids to create with and enjoy the next year.”
Rising fifth grader Ella S. echoes the unique experience of arts and crafts at Camp, saying, “I like arts and crafts because you can’t do Beadie Buddies anywhere else. It’s really entertaining to do with your friends.”
In addition, Chin Ng has also taken on the role of charting and distributing each year’s participation in the annual Polar Bear Swim, which challenges students to crawl out of their cabins at 7am and join in an early-morning plunge into the pool. These bold adventurers are acknowledged each year at the final day’s campwide gathering, receiving a token of their feat in the form of some variation of a small stuffed polar bear or a special gift if they never missed a year, a tradition and validation that many eighth graders eagerly await and one that Belcher remembers fondly.
“One of my favorite camp memories is participating in the Polar Bear Swim,” says Belcher. “I took part in this activity for all nine years that I attended camp. After swimming, my friends and I would relax while enjoying hot chocolate together. I also remember the special closing assembly for eighth graders where we received our polar bear pins for participating since kindergarten!”
As the Camp Live Oak tradition
goes strong, it can be easy to take for granted the invaluable community-building opportunity it provides Live Oak. While many other activities and events throughout the year at Live Oak are aimed at building relationships, there is something unique about extending these connections beyond the classrooms, beyond campus, and beyond our normal environments. Without this yearly cap to the school year, there would certainly be a big hole to fill.
“We would miss the community,” says Chin Ng. “We would miss the intergenerational part of it with all the kids in all the grades being able to be together. It’s also a time that brings families together. It’s a time to have the whole school together just being able to enjoy the experience together.”
Walk around and talk with any student, parent, or staff member about Camp and you will surely hear a trove of memories that stand out. Each year adds layers to these memories, building a rich experience that carries with it real meaning and significance.
“When I think about Camp Live Oak, I remember feeling happy,” explains Belcher. “I was surrounded by my friends, trying new activities, and enjoying everything each day had to offer. Sometimes my parents would volunteer, which made the experience even more special because I got to share that time with them. Now, returning as an adult fills me with nostalgia. I see my younger self reflected in my students as they experience Camp Live Oak. It’s a beautiful full-circle moment to witness them creating memories like the ones that have stayed with me all these years.”











The tradition of going to camp begins at the end of Live Oak’s first year in existence. Families spent three days and two nights together at Camp. Campers rowed boats in the creek, ziplined, and more. The outing featured mostly teacher-led activities. A teacher was in charge of organizing the camp, while different teachers took on that responsibility each year. Teachers were in charge of their classes in the morning and then the students had the choice of arts and crafts, sports, and swimming in the afternoon.

Live Oak moves to Camp Bothin in Marin.
Live Oak outgrows Camp Cazadero and spends its first year at Camp Swig, which featured a tennis court, among other activities.

1988
Live Oak finds its first long-term location for camp–Camp Cazadero. The school was gradually expanding, necessitating moves to bigger camp locations.


Up until this time faculty would stay overnight in the cabins with their classes. This evolved to the current model where parent volunteers spend the night in the student cabins.



Live Oak moves to Camp Newman in Santa Rosa. With Live Oak’s expanded student body, parents, faculty, and administrators lead a committee called “Camp Figure It Out” to determine if the school tradition should continue and if so, to find a location to accommodate us all.




The Covid-19 pandemic forces a shift to “Camp at Home,” a virtual camping experience held over Zoom. The Live Oak community got creative in maintaining the usual Camp traditions, such as the Polar Bear Swim where students recorded themselves jumping into a body of water of their choice: pools, lakes, bathtubs, and more. Students got creative in making their own Polar Bear Plunge recognition tokens. In addition, Beadie Baby kits were assembled and sent home to each student to keep their Camp arts and crafts spirit going strong.

Camp Newman sadly burns to the ground in the Tubbs Fire. Camp Jones Gulch had grown in the time since Live Oak last attended and was able to accommodate the school’s return to the redwoods.

Live Oak outgrows Camp Swig and heads to Camp Jones Gulch. Signaling a shift from the teacher-led camp experience, most of the activities at Camp Jones Gulch were led by the camp staff. Unlike now, when Camp occurs between Memorial Day weekend and step up and graduation in June, the school year used to end at Camp, with graduation happening beforehand.



Continuing to navigate the effects of the pandemic, Live Oak hosts “Camp at School.” Campers did field day activities led by eighth graders at Jackson Park and throughout the Mariposa Street Campus.
For the first time Live Oak’s campers are not all together. Renovation taking place at Camp Jones Gulch forces half of Live Oak’s students and families to stay at another YMCA camp nearby, Loma Mar, while the other half remains at Camp Jones Gulch. Loma Mar campers would drive back and forth to Jones Gulch and take part in activities during the day. Campers at Loma Mar took the Polar Bear Plunge in the chilly waters of nearby Pescadero Creek.

Camp Live Oak continues to bring the Live Oak community together at Camp Jones Gulch in late May with over 400 students, many parents and guardians, and the entire Live Oak faculty and staff in attendance. Eighth graders begin the tradition of tent camping on the field formerly designated as Tent City for parent camping. Parents, guardians, and siblings of students in attendance now set up camp at Memorial Park just down the road.



In this issue of Live Oak Magazine, we highlight the experience of one Live Oak family whose deep sense of purpose and belonging is expressed through the joy their children experience every day.

“I asked my son, “What do you love most about your school?” And he responded, “Because everyone is welcomed.””
I chose Live Oak School for my children well before I even had them. Yes, I realize how that sounds–it’s not so crazy once people realize that I’m a preschool director, and helping families transition to elementary schools is actually a key part of my job. I have knowledge of many different schools (there are so many in SF!), yet Live Oak was the only one I applied to because the mission of Live Oak aligned so much with my own values, especially as an educator.
In early education, we often talk about how a child’s environment is their third teacher, along with the adults and peers in their lives. A strong school environment with thoughtfully arranged spaces, accessibility to materials, and a positive school climate is a quiet force that encourages curiosity, creativity, independence, and collaboration. The first time I stepped into Live Oak School, I could feel the silent but powerful force within the staff, in the student art along all the walls of three entire floors, in the classrooms with wiggle chairs, in the lunchroom with headphones, in the breakout spaces outside the classrooms, and in the students with the “shout out” wall. And when I became a parent at the school, it was even more evident.
At Live Oak School, every decision is made with intention. For example, lunch is included in tuition for every child. By having every student eat the same meal, no child feels ostracized for eating school lunch. The days are on a six-day rotation so the children can have access to more daily programs instead of limiting it
to a five-day week. They created Groves, where a child from every grade and staff members are a part of a group for their entire time at the school to promote inclusivity. When my child walks around the school, kids from all the grades greet him and when he was a kindergartener, it made a larger school a little less scary.
Every child has strengths and areas of growth and mine is no exception. As a parent, I wanted a school that would challenge an academically advanced fiveyear-old, but would also support his socioemotional needs. Live Oak has exceeded my expectations. Because there are two credentialed teachers in every classroom, individualized learning can be achieved. I knew that this closer teacher-student ratio would allow my son to thriveand he has. The teachers have met him at his developmental level and supported him to reach higher goals, without having to potentially wait for any peers to catch up. In the same way that no children get left behind, Live Oak does not prevent kids from soaring to their potential. Even in kindergarten, my child was placed in a group with kids of similar literacy development where he would continue to be challenged in reading and writing. And now in Second Grade, he is writing lab reports along with writing Pour quoi tales!
I am a big advocate for mindfulness in the early years and I have been so impressed with the SEL program. My child has a lot of anxiety that can lead to bad thoughts but every time he gets one, he is taught to use his “Bubble Breath.” He takes his deep breath and imagines a bubble with the bad thought inside of it and when he is ready to pop it, he pops it to let it go. I love it so much, I use it too. Now, he’s able to identify his “big” feelings, process them, and respond appropriately with so many “tools” in his social toolbox after being at Live Oak for three years.
I asked my son, “What do you love most about your school?” And he responded, “Because everyone is welcomed.” The best part of the school is that the kids not only feel safe but supported in their individuality journey. As a parent, you could not ask for more. Live Oak School continues to check all my boxes and I feel so lucky to be a part of this compassionate community. This really would have been my dream school as a child and an environment I wish for every child.






“I have learned that there is one question that I must always ask myself every time I face a challenge: is this a problem, or is this just change? It’s human nature to see them as one and the same, but the more we understand that, the more we can accept that change can sometimes be evolution (and I, for one, am grateful to be a human standing up on this podium, and not an amoeba).”
Pascale Coppola ‘25, Eighth Grade Speaker


“Without our kindergarten classes’ extensive use of the Muni transit system, and the freedom we had as five-year-olds to explore the diverse neighborhoods of our city, I do not think I would be on the same path today as I am now, with the intention of studying sustainable urban planning next year in college. As you enter this next phase of your academic journey, I want you all to know that, even if you don’t have any idea what you ultimately want to do, your experiences at Live Oak… have given you the unique ability to embrace what makes you unique and spread your roots far.”
Max Borgiotti ‘21 Alumni Speaker


“Whether you’ve been here since day one or just joined us this year, you’ve consistently impressed me with your willingness to say yes. Yes to helping younger peers tackle academic challenges through peer tutoring. Yes to spreading joy by showcasing your talents in assemblies, musical performances, middle school plays, and talent shows. Yes to stepping up as changemakers through countless student-initiated and student-led projects. Yes to giving your all in academics, athletics, and extracurriculars. And yes, especially, to being role models for our younger students. Thank you for showing up and saying yes to being part of this community every single day.”
Nicole Zaheed P’25, Faculty Speaker
“Over my nine years here I’ve gotten to encounter so many things I never expected… Just as importantly, Live Oak has educated me to be a more virtuous person; it has taught me that kindness always matters. Live Oak has also taught me to have integrity in everything I do. When encountering something immoral, supporting others to understand unintentional consequences makes the world one step closer to righteousness.”
Mikaela Ho ‘25, Holly Horton Award Recipient









Graduates from the Class of 2025 are making an impact at the following high schools:
Skyline High School
The Bay School of San Francisco
The College Preparatory School
Convent & Stuart Hall
Lick-Wilmerding High School
Sacred Heart Cathedral Preparatory
Saint Ignatius College Preparatory
Washington High School
Urban School of San Francisco
San Francisco University High School
Terra Nova High School
Raoul Wallenberg High School
The International School of San Francisco
Menlo School
Whitefish Bay High School
Drew School



Nala was selected to participate in an Ethnic Studies Working Group over her four years at Lick. Nala and her team’s goal was to make Ethnic Studies a graduation requirement for all students at Lick. She advocated for the importance of Ethnic Studies to the school community, helped craft the curriculum for the pilot class, hosted forums for students to give input, refurbished the working group mission statement, and nominated students to lead when the seniors graduate. Additionally, she co-led a community meeting about Indigenous Art which included inviting an artist to speak about her art, her indigeneity, and how to use one’s voice for others. The Ethnic Studies course will launch in fall 2025.





Justin participated in student government over his four years at Drew School and created a pipeline of future student leaders whom he mentored. In his role as student body vice president, he created seminars on independent problem solving, conflict management, prioritizing, and public speaking. Additionally, he worked on The 415, a school-wide music and food festival that hosts 500+ attendees. As manager of the Student Cafe, he donated the profits back to the school to subsidize event fees such as prom tickets. As co-founder of Drew’s Geography Club, he worked to create intercultural understanding and appreciation among its members. As an Admissions Intern, he worked on New Student Night which he transformed into an interactive experience that better aligns with the experiential pedagogy Drew.

Watch our video about Nala and Justin

Have an alumni update? Know a future Alumni Changemaker? We are always looking for opportunities to connect with and share about our alumni. Email advancement@liveoaksf.org with an update.
Live Oak invited Nala and Justin to speak to middle school students at a special assembly on Changemaker Day in January. The annual event provides Live Oak students with a window into the impactful work that our Young Alumni Changemaker honorees are doing in their high school communities and beyond. Nala and Justin spent the morning visiting classrooms to share about their service efforts, provide advice, and catch up with many of their former teachers. We are proud of their commitment to making positive change and are eager to see how their influence helps guide the next generation of changemakers at Live Oak.





“Going to a public elementary school, you don’t really hear the word changemaker a lot. Once I got to Live Oak, I was seeing how people were changemakers and it was like you don’t have to make change by changing the whole world in one day; you can make change within your own world.”
Nala Urrutia ‘21


“What I have learned is that people working together can make so much more change than people working alone. What I want to do in the future for people wherever I am is to prove to them that they can make change–that anyone can make change–and that together we can build a much better society; I really believe that.”
Justin Babler-Kuebler ‘21
We welcomed members of the Live Oak Class of 2021 back to campus in mid-May for a chance to reconnect with each other and some of the spaces on campus that hold so many memories for this group. We wish these alumni the best as they transition from high school to college this fall!
Live Oak graduates from the Class of 2021 and beyond are making an impact at the following colleges and universities:
American University
Art Center College of Design
Bard College
Barnard College
Bates College
Boston College
Brown University
Cal Poly Pomona
Cal Poly San Luis Obispo
Carleton College
Carnegie Mellon University
Case Western Reserve University
Champlain College
Chapman College
Colby College
Colorado College
Colorado University Boulder
Columbia University
Cornell University
Emory University
Evergreen State College
George Washington University
Harvard University
Haverford College
Johns Hopkins University
Julliard College
Loyola Marymount University
Loyola University New Orleans
Mount Holyoke College
Northeastern University
New York University
Oberlin College & Conservatory
Olin College of Engineering
Oregon State University
Pitzer College
Pomona College
Reed College
San Francisco State University
San Jose State University
Santa Clara University
Scripps College
Seattle University
Smith College
Stanford University
Syracuse University
The New School
Tufts University

Tulane University
University of Arizona
University of California Berkeley
University of California Davis
University of California Los Angeles
University of California Santa Barbara
University of California Santa Cruz
University of Chicago
University of Maryland
University of Michigan Ann Arbor
University of Oregon
University of Rochester
University of Southern California
University of St. Andrews
University of Texas Austin
University of Washington
University of Wisconsin
Wake Forest University
Washington University St. Louis
Wellesley College
Wesleyan University
Whitman College
Whitney College
Williams College
Yale University

DeWayne Colbert ‘24 joined the flag football team at Lick-Wilmerding High School this past fall, starting off as a starter for both offense and defense on the JV squad before being moved up to varsity where he was a member of the starting defense. This past spring, D3 contributed to Lick’s 4x100 relay team that earned second-team All-BCL West track and field honors.
Diego Villegas ‘16 works as a college access assistant at Mission Graduates, supporting First-Gen students in navigating the college application process. After graduating from Live Oak, Diego did theater at Drew School and with Live Oak Drama Teacher Stephanie Temple at New Conservatory Theatre Center, performing in classics like The Wizard of Oz while also creating a range of his own characters. In 2020, he starred in a web series called PuppyMind.
In addition to serving as student body president at Drew School, Lena Wilson ‘21 created and taught a Sports Management elective to teach students the fundamental aspects of high school sports manage ment. Outside of Drew, she interned at the Museum of Craft and Design to bring art to underprivileged communities, leading youth art workshops and curating 200 gift bags for the 2023 SF Pride Parade. She is carrying on her leadership skills at UC Berkeley in the fall of 2025.
Andrew Martinovsky ‘23 earned first-team All-BCL East honors in the 800m following his sophomore track and field season at the College Preparatory School.
Ethan Kraska ‘23 capped off his sophomore track and field season at University High by taking home first-team All-BCL West honors as part of the 4x400m relay, while University teammate and fellow Live Oak alum Ben Friedland ‘23 earned second-team recognition in the 3200m.
Fitz Brockway ‘21 rounded out his high school lacrosse career by earning first-team All-BCL West honors for University High School.




Natalie Babler-Kuebler ‘23 took home second-team All-BCL West honors in softball this past spring after a strong sophomore season at the Urban School where she played left field and pitcher.

Each spring, Live Oak opens its doors to welcome the special people in our students’ lives on Grandparents & Special Friends Day. This tradition has long been a way for our students to share about their school days, introduce their teachers and peers, and give their special guests a glimpse into the numerous ways they have been learning and growing throughout the year. Grandparents & Special Friends Day helps develop meaningful connections within the broader Live Oak community that help add depth to our students’ school experience. This year, in addition to showing their guests around campus, students played games, created art, solved puzzles, wrote poetry, and engaged in so many fun activities that are sure to leave lasting memories for years to come.
We appreciate the support that our grandparents and special friends give by taking part in this annual tradition and we look forward to many more years of memories, experiences, and community building.




















Thanks to the generosity of the Class of 2025 and their families, Live Oak’s new STEM Labs—funded by this year’s 8th Grade Legacy Gift—are poised to transform how students experience science and math. These purposefully designed spaces will give students greater opportunities to engage in hands-on inquiry, crossdisciplinary thinking, and project-based learning that reflects the real-world challenges they’re eager to explore.
At Live Oak, science education begins with a student’s natural curiosity. The new labs are an investment in that curiosity, offering environments where learning isn’t limited by layouts or class transitions. With more time and space to carry out complex experiments, students will be better equipped to test hypotheses, problem-solve collaboratively, and connect their learning to current scientific issues.
“There’s something special about having a space curated for the type of learning you want to have happen,” shares Associate Head of School Tanya Susoev. “Rather than fitting the learning to the space, we’re designing a space that expands what’s possible.”
The vision for these new STEM Labs is about more than upgraded infrastructure—it’s about creating a setting where students can engage in meaningful, relevant, and at times, unexpected learning. As Susoev describes it, “We’re trying to do something that more deeply informs how our students engage in this space of curiosity, a space of the unknown. It allows them to leave Live Oak with a sense of purpose—and a deep understanding of why they learned science the way they did.”
From hydroponic plant systems that support studies in sustainable agriculture, to multiday engineering builds, the new labs support the kind of handson, immersive learning students
crave. Faculty are also using this opportunity to align curriculum more closely with the Next Generation Science Standards (NGSS), which emphasize both content knowledge and the development of key scientific practices and skills.
“We do a lot of inquiry-based investigations—students are encouraged to pursue topics they’re passionate about,” says Middle School Science Teacher Neil Cashman. “It’s amazing to see what they come up with when they have the space and resources to explore.”
In these labs, learning includes experimentation, failure, and iteration. Students will have opportunities to document and revisit their work, track progress, and adapt their thinking as they go—hallmarks of real scientific inquiry.
Ultimately, the new STEM Labs reflect Live Oak’s commitment to equipping students with the tools and mindsets to better understand and shape the world around them. As Cashman puts it, “Science is never static—it’s always evolving. And so are our students.”
Thank You for Supporting The
Nasser & Cady Gonzalez Abdulkariem
Stephen & Leah Allen Apple
Roy & Sara Bahat
Keith & Roseanne Barry Lara Bazelon
Aaron Bell & Sarika Singh
Rachel Bernstein
Radbert & Diana Chin
Andrew Clarke & Beth Rostan
Roman & Jenny Coppola
Matthew Dirkes
Molly Ditmore
David & Regina Eberhart
Daniel Ewing & Alison Ludwig
Matthew Flynn & Dominique Samuels
Peter & Heather Friedland
Rachel Garlin & Laela Sturdy Google
Rolland Ho & Rita Louh
Kevin & Sharmila Hutchins
Klara Kevane & Matthew Dobson
Xavier Lanier & Amisha Gandhi
Rikard Lindquist & Elin Hagstrom
Ciaran & Theresa Long
Theodore McCullough & Stephana Patton
Thomas Murphy & Timothy Murray
Macario Namie & Courtney Towle
Daniel Pan & Anna Lopez
Ishwar Parulkar & Athena Kashyap
Sunil Patel & Zankhana Patel
John & Artemis Patrick
Emma Peat & Jonathan Bercovitch
Andrew & Emily Perito
Karl & Kirsten Pfleger
Eros & Jaime Resmini
Jamie & Jacqui Roberts
Jerome & Rachael Sak
Sephora USA, Inc.
Andrew Smith
Audrey & Darius Soriano
Peter Suen & Michelle Yip
Rowan & Stephanie Trollope
Maria Urrutia
Brian Wey & Diana Lie
Andrew Williamson & Jill Jarrett
Brett & Kerry Wingeier
Nicole & Murshed Zaheed






Throughout the course of a school year Live Oak students refine existing skills, build new knowledge, and deepen their abilities in countless ways. This process and these results look different for each child, but they are all made possible by the Live Oak community’s commitment to supporting a one-of-a-kind education.
See







“A new skill I learned this year was how to talk to bigger groups of people. It will be very useful for me later on in life when I need to talk to people for my job. And I’ve gotten better at being more patient and learning how to express my emotions rather than holding them in.”
Andrew H. ‘27
what our students learned this past year and how their learning took them in some exciting new directions!


“I got a lot better at reading this year. I’ve been reading way more in general and I got into reading a lot of chapter books. For one assignment we had to read a book and summarize it, and I feel like I did a really good job of taking in all that information and sharing what I read.”
Bode G. ‘29







“I have really improved in my math. I can see how much better I’ve been this year. At the start of the year I needed a lot of help. I know it’s not a race, but I get my work done faster now and feel like that is a good reflection on how much I have gotten better.”
Naomi S. ‘29



“My favorite thing I learned about this year was ancient China, which was the civilization that I researched. It was fun because we got to make our own lesson plans and do a lot of research. It was the biggest research project that I’ve done so far.”
Arhan C. ’27




Check out this video of our students sharing some of their favorite units and the ways they grew over this past year.

“I grew the most in math. I learned new strategies, like ‘carry the one,’ which I know will make me more efficient doing math in the future.”












“One of my favorite things we learned about was in social studies when we learned about women changemakers because I really liked seeing all the positive things that women
“My favorite thing that I learned about was water and nature because I like learning about the things that live there. It’s cool just to watch how things grow. The field trips we went on were all new experiences too. I went on a ferry for the first time.”
Elio S. ’33

“We had a chemistry unit and I learned how different chemicals interact together. It was definitely one of my favorite units because I’ve always wanted to learn more about chemistry and what happens when you mix different elements together.”
Amelia W. ‘28




“I really liked learning math, especially in the afternoons when we would take turns sharing an equation that added up to the number of days we had been in school at that point. My friend always had really good equations and he would share with me, so it was fun getting to learn more from my classmates.”
Tanay K. ‘32
Over the years, Live Oak students, faculty, and families have grown accustomed to hearing a common adage: Mistakes Are Magic.
The sentiment behind the phrase echoes of embracing the risk that comes with trying and failing. A fundamental tenet of Live Oak’s academic program from kindergarten on is the affirmation that deep, transformative learning happens best when we learn from our mistakes. With this spirit of lifelong learning in mind, we are launching a new guest column for Live Oak Magazine giving voice to our faculty to highlight the times they have encountered challenges in their practice and experienced valuable growth because of it.

Teaching and learning are full of mistakes…mistakes that feel like disasters, mistakes that feel like lessons, mistakes that lead to new ideas, and mistakes that turn out to be wonderful! As much as we ask and expect our students to embrace mistakes, it’s just as important for teachers. It’s also important to be transparent about the mistakes you make so your students can see that it is part of everyone’s learning.
I make mistakes daily. From little ones like spelling a word wrong on the board to bigger ones like teaching the wrong information. I encourage my students to help me out when they notice a mistake. It’s a wonderful way for them to practice the skill of respectfully correcting someone. It’s common to hear a student say, “Holly, I think that word is spelled…” There are also times when you will hear me share with the students about a mistake I made.
During our last writing unit on persuasive writing, I taught about writing a counterargument. It’s always a tough lesson, so I tried something new this year. As soon as our class got to work, I realized that I didn’t teach it as well as I had thought. From their work, it was clear that they did not understand what a counter argument was and were just mimicking what I wrote in my example. When school ended that day, I talked with my co-teacher to brainstorm another way to approach this lesson. I also connected with the other third grade teachers next door to see how the lesson went in their room, to continue to brainstorm and share my new idea.
The next day, I tried again. Before I started the lesson, I shared with them why I was trying again. I could tell that the way I taught them was confusing,
and I wanted to try again. Right away, their hands were in the air, encouraging me and telling me it was okay. I tried it again in a new way and instantly saw the light bulbs go on for many kids. But since it was the second time teaching the same thing, there were some kids who just seemed more confused. When the class went off to work, I called over a small handful of students who I could tell needed a little more support. It was important for me to clarify that this was a mistake that I made and that I was sorry for confusing them. Because I was honest with them, they were able to take the pressure off of themselves, take a deep breath, and try again. The culture that we created and nurtured in our classroom allowed me to be comfortable sharing my mistakes with my students and hopefully allowed them to share theirs with more confidence.


We believe deeply in the symbiotic relationship between each individual and their communities—their school, their neighborhood, their city, and ultimately the whole world.
Our Mission and Values emanate out from that essential truth — helping the individual access everything that they need to flourish necessarily benefits the entire group, and practicing compassion for those around us necessarily benefits each individual.














